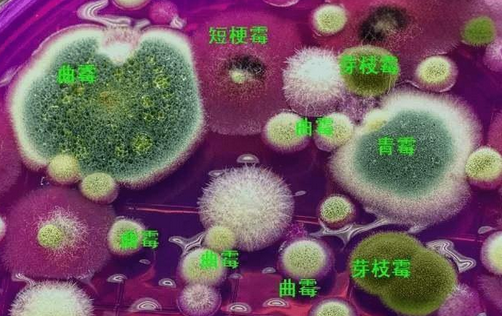
1.png

行业新闻
微生物致病菌检测仪:守护食品安全的重要利器
welhome彩神作者:莱恩德atp检测仪 访问:798 时间:2024-06-04
随着人们对健康的日益重视,食品安全也成为人们关注的焦点。在食品安全中,微生物污染无疑是一个重要的隐患。为了保证食品的安全,我们需要一种有效的检测微生物污染的工具,那就是微生物病原体检测仪器。那么,微生物病原体检测器有用吗?本文将从以下几个方面进行论述。
首先,微生物病原体检测仪具有精度高、效率高的特点。传统的微生物检测方法通常需要实验室条件和专业技术人员,操作复杂耗时。微生物病原体检测仪采用先进的传感器技术和自动检测流程,可以在短时间内完成大量样本的检测,大大提高了检测效率。同时,其高精度的检测结果也使假阳性率大大降低,更加可靠。
其次,微生物病原体检测仪是无创的。在传统的微生物检测方法中,如培养法和聚合酶链式反应法,需要对样本进行切割或侵入性操作,这对人体有一定的伤害风险。微生物病原体检测仪不需要任何切割或侵入性操作,既保护了人体,又保证了检测的准确性。
此外,微生物病原体检测仪的应用范围也很广。它不仅可以用于食品的初步筛选,还可以用于医学、饮用水、环境等领域的微生物污染监测。这使得它在确保食品安全的同时,为其他领域的微生物污染控制提供了强有力的技术支持。
然而,尽管微生物病原体检测器有许多优点,但我们不能忽视它的问题。例如,它的价格相对较高,可能无法满足一些大规模的检查需求。此外,设备的维护和校准也需要专业技术人员进行,否则可能会影响测试结果的准确性。
welhome彩神 总的来说,微生物病原体检测仪是一种非常有用的工具,它以其高精度、高效率、非侵入性和广泛的应用为我们提供了一种有效的方法来检测微生物污染,并确保食品和其他领域的安全。虽然存在一些问题,但随着技术的发展和成本的降低,这些问题有望得到解决。因此,我们可以期待微生物病原体检测仪在未来的发展中发挥更大的作用。





